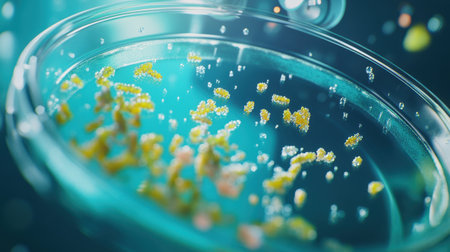
Close-up of a Petri dish growing bacterial culture, under a microscope in a laboratoryの素材

素材 - Close-up of a Petri dish growing bacterial culture, under a microscope in a laboratory
作品情報
Close-up of a Petri dish growing bacterial culture, under a microscope in a laboratory
- ID:255442959
- 作品種別:
- 作者名:sawat burarat
キーワード
- analysis
- analyzing
- bacterium
- biology
- circle
- clean
- clinical
- color image
- controlled
- crockery
- culture
- cultures
- cut out
- diagnostic
- discovery
- dish
- equipment
- exam
- experiment
- exploration
- foundation
- fungus
- gelatin
- glove
- growth
- hand
- health care
- healthcare and medicine
- holding
- horizontal
- hygiene
- illness
- innovative
- inspiration
- laboratory
- light
- medicine
- microbiology
- microscopic
- no people
- nutritional
- research
- safety
- sample
- science
- scientist
- study
- technology
類似作品
Chef plating a ...
A street food v...
A chef tossing ...
Chef garnishing...
Classic Pasta o...
Woman at the ta...
A person holdin...
Close-up of fem...
A close-up shot...
A chef tossing ...
This vibrant im...
A chef preparin...
Volunteer conce...
A man is cookin...
person, making ...
A close-up of a...
Poor people car...
A close-up of a...
Delicate steam ...
Waiter carrying...
A beautifully p...
Volunteers come...
A chef garnishi...
Female hands ho...
charity food fo...
Enjoy a delecta...
Free food for t...
Papaya salad
The wealthy ric...
Hands with a wh...
A beautifully p...
Cheese soup in ...
Close-up of a S...
A person scoopi...
A street vendor...
A sizzling plat...
Wild forest mus...
Beautiful happy...
Stunning modern...
There is a sala...
Close-up of del...
fried eggs frie...
Professional ch...
Menemen, turkis...
A chef tossing ...
The hand of the...
Helping Feed th...
a hand holding ...
Close up to del...